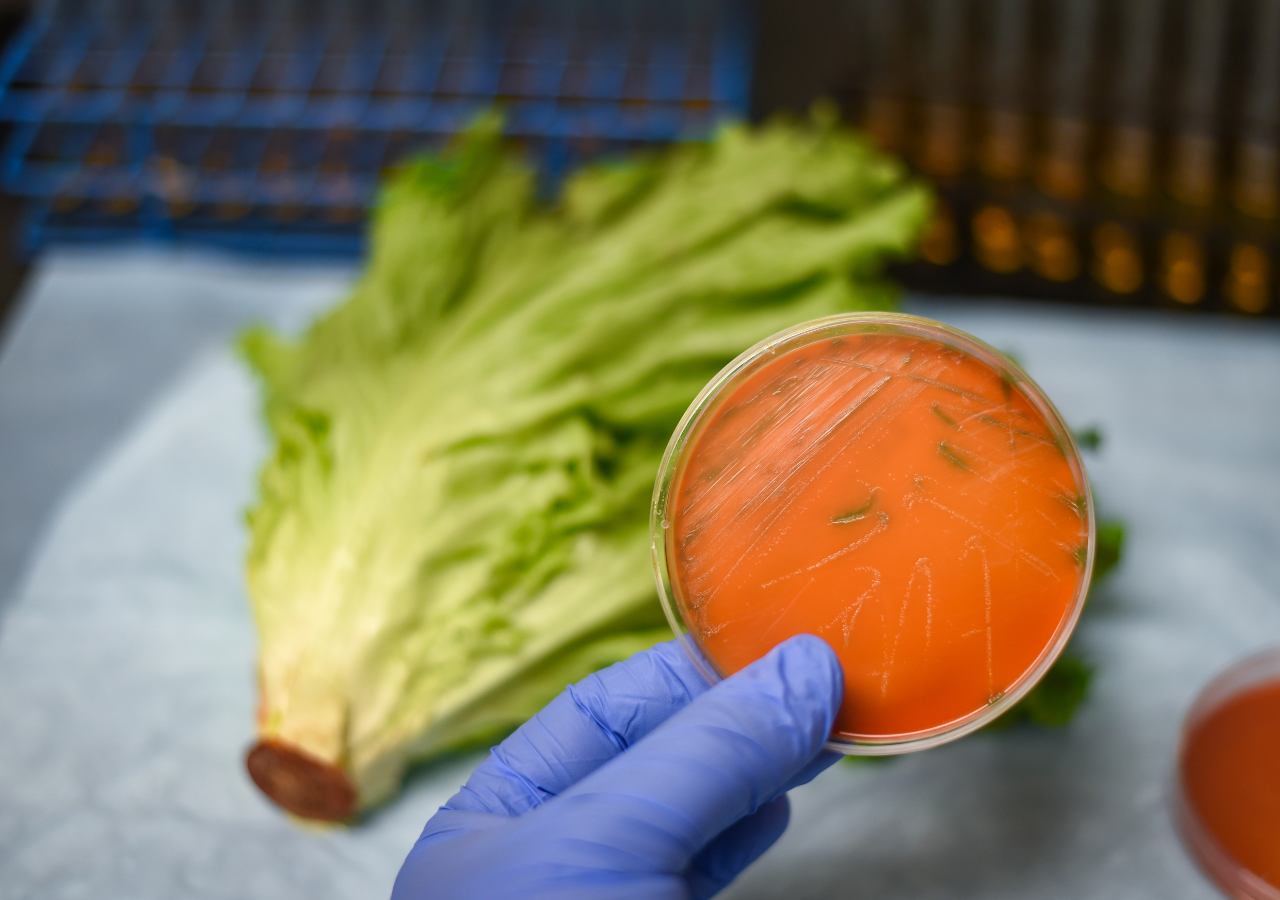

Obavy o nedostatek hnojiv na pěstování zemědělských plodin v důsledku války v Perském zálivu jsou zatím předčasné, uklidňují odborníci. S pozvolným růstem ceny potravin je ale potřeba počítat v dlouhodobějším horizontu, pokud se konflikt protáhne. Nejvíc se na něm podepíše tak jako u jiného zboží rostoucí cena pohonných hmot.
Výrobci potravin i zemědělci však uklidňují, že v nejbližším období žádná lavina zdražování ve větším měřítku nehrozí. Ohledně příštího roku si však v případě, že se konflikt na Blízkém východě protáhne, ale již tak jisti nejsou. „Podle informací od zemědělců jsou hnojiva pro letošní sezonu již nakoupená, takže ohrožení letošní sklizně v Česku není kritické. Situaci však ovlivní nákupy hnojiv pro podzimní setí a pro příští rok,“ uvedl pro Deník.cz mluvčí Potravinářské komory Marek Zemánek.
Nebudou tedy na českém trhu nějaké druhy potravin kvůli válce chybět? Jak Zemánek potvrdil, Evropská unie jako celek je téměř ve všech základních komoditách soběstačná. „Scénář prázdných regálů tedy nehrozí. U určitých položek však může dojít k dočasným lokálním výpadkům,“ připustil Zemánek. Kvůli narušeným logistickým trasám z Asie a Perského zálivu proto nevylučuje například omezenou dostupnost konkrétních značek rýže nebo vybraných druhů koření.
Dále zde: https://www.denik.cz/ekonomika/zemedelstvi-hnojiva-potraviny-ceny-valka-pohonne-hmoty-analytici.html